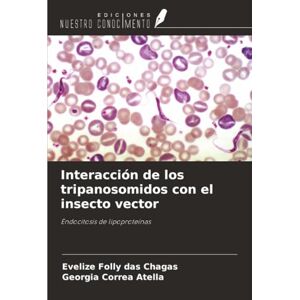
Folly das Chagas, Evelize Interacción de los tripanosomidos con el insecto vector: Endocitosis de lipoproteínas Folly das Chagas, Evelize Interacción de los tripanosomidos con el insecto vector: Endocitosis de lipoproteínas

Offers updated on: 24/12/2025. Paid and non-exhaustive ads. ★ The ratings are generated from multiple sources, including data provided by the merchant and publicly available information.
Due to technical constraints, Kelkoo cannot guarantee the complete accuracy, nor the completeness of the information provided by the merchants. As a result, and due to the nature of Kelkoo's activities, in the event of discrepancies between the information displayed on the Kelkoo website or ads and the one displayed on the merchant's website, the latter will prevail. Prices shown are including all fees. - Learn more